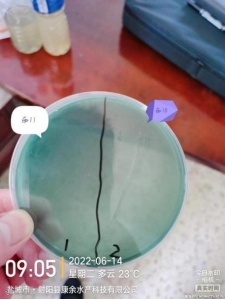
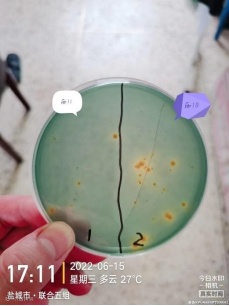
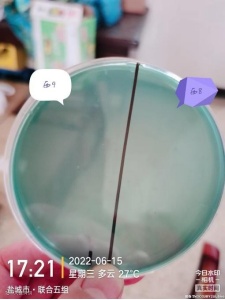
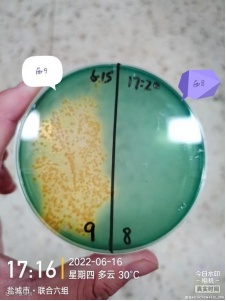
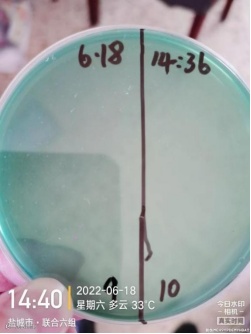

“弧光”在对虾养殖控制弧菌的实验报告
1、实验塘口:西 8、西 9、西 10、西 11
2、第一次检测:6 月 14 日上午对西 10(左 1)、西11 号(右 2)塘进行弧菌检测,检测结果显示西 10号塘平板基本看不到弧菌,西 11 号塘有少量黄弧菌和绿弧菌,其中黄弧菌多于绿弧菌:

3、第二次检测:6 月 15 日下午 17 点对西 8(右)、西9(左)号塘进行涂平板检测,西 8 号塘基本没有检测到弧菌,西 9 塘口平板上有很多的黄弧菌,说明黄弧菌超标,同时对虾有吃料慢的现象。

4、产品使用:于 6 月 17 日上午 8 点-9 点在西 9、西10 两个塘口使用本产品,两个塘口均为水深 1.4 米, 水面积 4 亩,每个塘口使用本品 40g 化水全池泼洒。西 9 号塘:水面 4 亩、水深 1.4 米


西 10 号塘:水面 4 亩,水深 1.4 米


5、用后检测:使用本品 30小时后进行涂平板检测:刚涂平板(左)、涂平板 10小时后(右)

6、后续处理:于 6 月 19 日对西 9、西 10 号塘补充净水肽菌。
7、实验结果:在使用弧光后 30小时 对水体进行涂平板检测,检测结果显示弧菌大量减少,西9 塘口基本没有检测到弧菌,西 10 塘口仅两个绿弧菌菌落,证明水体弧菌数量大幅度减少,于 6 月 19 日上午 8 点对两个塘口补充净水肽菌,西9 号塘口吃料恢复正常。


总结:本品使用后约 30-36小时 可最大幅度降低水体有害弧菌数量,是最佳的平板检测时间;弧菌数量降低之后,应尽快补充有益菌抢占弧菌生存空间,以防止弧菌反弹;效果表现一方面是涂平板检测弧菌数量减少,另一方面是对虾活力和吃料情况恢复正常。




